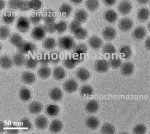
PEG-Modified Upconverting Nanoparticles

PEG Modified Upconverting Nanoparticles
Upconverting Nanoparticles and Quantum Dots
Category: PEG Modified Upconverting Nanoparticles
Concentration: 1mg/mL to 20 mg/mL (in stock)
Concentration Customization: Possible
Carrier: Water
Dispersion Customization: Possible
Size: 10 mL – 100 mL, 1 mg to 100 mg
Nanochemazone also provides larger package size. Contact us for more information.
Price: Inquiry (sales@nanochemazone.com)
| Chemical Name | PEG-Modified Upconverting Nanoparticles |
| Catalog code | NCZ-UCNP-103 |
| Appearance | white solution |
| Solvent | Water |
| Excitation wavelength | 975 nm |
| MF | NaYREF4(RE: Yb, Er, Tm, Gd, Mn, Lu) @PEG |
| CAS Number | 7681-49-4(Sodium fluoride) |
| Sensitizer | Ytterbium (Yb3+) |
| Concentration | 5 mg/mL, Concentration Customization: Possible |
| Particle Size and Morphology | 35 nm, nanosized spheres |
| Surface Modified | PEG |
| Form | Dispersion/Powder |
| Activator | Emission wavelength | Fluorescence |
| Thulium (Tm3+) | 365/475 nm | Purple-Blue |
| Erbium (Er3+) | 545/660 nm | Green-Yellow |
| Thulium (Tm3+) | 804 nm | Near-infrared |
The doping concentrations are optimized, leading to strong upconverted emissions at specific wavelengths. The size of UCNs can be customized based on user’s need. The UCNs are of high quantum efficiency and very photostable. After proper surface modification and functionalization, the products can be used for fluorescence imaging, biodetection, photodynamic therapy and photoactivation of anti-cancer drugs and biomolecules.
| Product Number | Em. Wavelength | Color | Crystal Formula | Diameter | Morphology | Amount (mg) |
| NCZ-UCNP-103-365 | 365 nm | UV | NaYREF4 | 25 nm | Spherical | 10/20/50 |
| NCZ-UCNP-103-475 | 475 nm | Blue | NaYREF4 | 25 nm | Spherical | 10/20/50 |
| NCZ-UCNP-103-545 | 545 nm | Green | NaYREF4 | 25 nm | Spherical | 10/20/50 |
| NCZ-UCNP-103-660 | 660 nm | Red | NaYREF4 | 25 nm | Spherical | 10/20/50 |
| NCZ-UCNP-103-804 | 804 nm | NIR | NaYREF4 | 25 nm | Spherical | 10/20/50 |
Application
Upconverting nanoparticles have excellent photostability and have been widely used in biomedical applications, including in vitro bioimaging, in vivo bioimaging, bioassays, immunohistochemistry, microarray detection, photodynamic therapy, and photo-controlled drug activation.
Upconverting nanoparticles are able to convert near infrared radiations with lower energy into visible radiations with higher energy via a nonlinear optical process. The doping concentrations and the size of upconverting nanoparticles can be customized based on your specific requirements.
Our upconverting nanoparticles can either be oil or water dispersible. By precise surface modification, upconverting nanoparticles are available with coated, amine functionalized and antibody conjugated forms. These photoluminescent nanoparticles can be used for bio-imaging, molecular recognition and photodynamic therapy.
- Molecular recognition
- Highly sensitive bioimaging
- Biosensors
- Light-responsive drug release
- Photosensitizers in photodynamic therapy
- Immunoassay
- Flow cytometry
Other information
Storage: sealed, stored at 4-8 °C
Validity: 6 months
Note: For pricing & ordering information, please contact us at sales@nanochemazone.com
Please contact us for quotes on Larger Quantities & Customization. E-mail: contact@nanochemazone.com
Customization:
If you are planning to order large quantities for your industrial and academic needs, please note that customization of parameters (such as size, length, purity, functionalities etc.) are available upon request.
Only logged in customers who have purchased this product may leave a review.
Related products
Oil Dispersible Upconverting Nanoparticles
Upconverting Nanoparticles and Quantum Dots
Category: Oil Dispersible Upconverting Nanoparticles
Concentration: 1mg/mL to 20 mg/mL (in stock) Concentration Customization: Possible Carrier: Cyclohexane Dispersion Customization: Possible Size: 10 mL – 100 mL, 1 mg to 100 mg Nanochemazone also provides larger package size. Contact us for more information. Price: Inquiry (sales@nanochemazone.com)| Chemical Name | Upconverting nanoparticles/Quantum dots |
| Catalog code | NCZ-UCNP-102 |
| Appearance | yellowish or light brown solution |
| Solvent | Cyclohexane |
| Excitation wavelength | 975 nm |
| MF | NaYREF4(RE: Yb, Er, Tm, Gd, Mn, Lu) |
| CAS Number | 110-82-7 (Cyclohexane), 7681-49-4(Sodium fluoride) |
| Sensitizer | Ytterbium (Yb3+) |
| Concentration | 5 mg/mL, Concentration Customization: Possible |
| Particle Size and Morphology | 25 nm, nanosized spheres |
| Surface Modified | Oleic acid |
| Activator | Emission wavelength | Fluorescence |
| Thulium (Tm3+) | 365/475 nm | Purple-Blue |
| Erbium (Er3+) | 545/660 nm | Green-Yellow |
| Thulium (Tm3+) | 804 nm | Near-infrared |
The doping concentrations are optimized, leading to strong upconverted emissions at specific wavelengths. The size of UCNs can be customized based on user’s need. The UCNs are of high quantum efficiency and very photostable. After proper surface modification and functionalization, the products can be used for fluorescence imaging, biodetection, photodynamic therapy and photoactivation of anti-cancer drugs and biomolecules.
| Product Number | Em. Wavelength | Color | Crystal Formula | Diameter | Morphology | Amount (mg) |
| NCZ-UCNP-102-365 | 365 nm | UV | NaYREF4 | 25 nm | Spherical | 10/20/50 |
| NCZ-UCNP-102-475 | 475 nm | Blue | NaYREF4 | 25 nm | Spherical | 10/20/50 |
| NCZ-UCNP-102-545 | 545 nm | Green | NaYREF4 | 25 nm | Spherical | 10/20/50 |
| NCZ-UCNP-102-660 | 660 nm | Red | NaYREF4 | 25 nm | Spherical | 10/20/50 |
| NCZ-UCNP-102-804 | 804 nm | NIR | NaYREF4 | 25 nm | Spherical | 10/20/50 |
Application
Upconverting nanoparticles have excellent photostability and have been widely used in biomedical applications, including in vitro bioimaging, in vivo bioimaging, bioassays, immunohistochemistry, microarray detection, photodynamic therapy, and photo-controlled drug activation.
Upconverting nanoparticles are able to convert near infrared radiations with lower energy into visible radiations with higher energy via a nonlinear optical process. The doping concentrations and the size of upconverting nanoparticles can be customized based on your specific requirements.
Our upconverting nanoparticles can either be oil or water dispersible. By precise surface modification, upconverting nanoparticles are available with coated, amine functionalized and antibody conjugated forms. These photoluminescent nanoparticles can be used for bio-imaging, molecular recognition and photodynamic therapy.
- Molecular recognition
- Highly sensitive bioimaging
- Biosensors
- Light-responsive drug release
- Photosensitizers in photodynamic therapy
- Immunoassay
- Flow cytometry
Water Dispersible Upconverting Nanoparticles
Upconverting Nanoparticles and Quantum Dots
Category: Water Soluble without Ligand or without Surface group Modification
Concentration: 1mg/mL to 20 mg/mL (in stock) Concentration Customization: Possible Carrier: Water Dispersion Customization: Possible Size: 10 mL – 100 mL, 1 mg to 100 mg Nanochemazone also provides larger package size. Contact us for more information. Price: Inquiry (sales@nanochemazone.com)| Chemical Name | Upconverting nanoparticles/Quantum dots |
| Catalog code | NCZ-UCNP-101 |
| Appearance | Ivory white solution |
| Solvent | water |
| Excitation wavelength | 975 nm |
| MF | NaYREF4(RE: Yb, Er, Tm, Gd, Mn, Lu) |
| CAS Number | 7681-49-4(Sodium fluoride) |
| Sensitizer | Ytterbium (Yb3+) |
| Concentration | 5 mg/mL, Concentration Customization: Possible |
| Particle Size and Morphology | 25 nm, nanosized spheres |
| Activator | Emission wavelength | Fluorescence |
| Thulium (Tm3+) | 365/475 nm | Purple-Blue |
| Erbium (Er3+) | 545/660 nm | Green-Yellow |
| Thulium (Tm3+) | 804 nm | Near-infrared |
The doping concentrations are optimized, leading to strong upconverted emissions at specific wavelengths. The size of UCNs can be customized based on the user’s need. The oleates have been removed from the nanoparticle surface through treatment with diluted hydrochloric acid, rendering UCNs dispersible directly in water and ethanol. The UCNs are of high quantum efficiency and very photostable. After proper surface modification and functionalization, the products can be used for fluorescence imaging, biodetection, photodynamic therapy and photoactivation of anti-cancer drugs and biomolecules.
| Product Number | Em. Wavelength | Color | Crystal Formula | Diameter | Morphology | Amount (mg) |
| NCZ-UCNP-101-365 | 365 nm | UV | NaYREF4 | 25 nm | Spherical | 10/20/50 |
| NCZ-UCNP-101-475 | 475 nm | Blue | NaYREF4 | 25 nm | Spherical | 10/20/50 |
| NCZ-UCNP-101-545 | 545 nm | Green | NaYREF4 | 25 nm | Spherical | 10/20/50 |
| NCZ-UCNP-101-660 | 660 nm | Red | NaYREF4 | 25 nm | Spherical | 10/20/50 |
| NCZ-UCNP-101-804 | 804 nm | NIR | NaYREF4 | 25 nm | Spherical | 10/20/50 |
Upconverting nanoparticles have excellent photostability and have been widely used in biomedical applications, including in vitro bioimaging, in vivo bioimaging, bioassays, immunohistochemistry, microarray detection, photodynamic therapy, and photo-controlled drug activation.
Upconverting nanoparticles are able to convert near-infrared radiations with lower energy into visible radiations with higher energy via a nonlinear optical process. The doping concentrations and the size of upconverting nanoparticles can be customized based on your specific requirements.
Our upconverting nanoparticles can either be oil or water-dispersible. By precise surface modification, upconverting nanoparticles are available with coated, amine-functionalized and antibody conjugated forms. These photoluminescent nanoparticles can be used for bio-imaging, molecular recognition, and photodynamic therapy.
- Molecular recognition
- Highly sensitive bioimaging
- Biosensors
- Light-responsive drug release
- Photosensitizers in photodynamic therapy
- Immunoassay
- Flow cytometry

Reviews
There are no reviews yet.